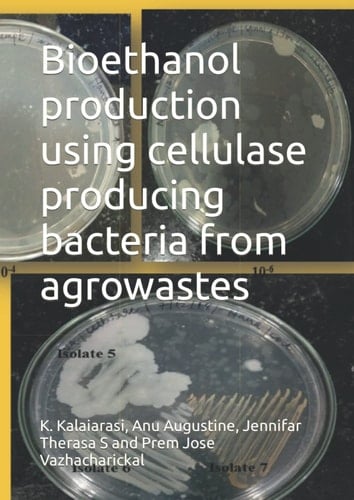
Bioethanol production using cellulase producing bacteria from agrowastes

Bioethanol production using cellulase producing bacteria from agrowastes
0
0
Author Description
Page Count:
55
Publication Date:
2022-02-18
ISBN-13:
9798419150317
Community Tags
Reader Comments
Share Your Thoughts
No comments yet. Be the first to share your thoughts!